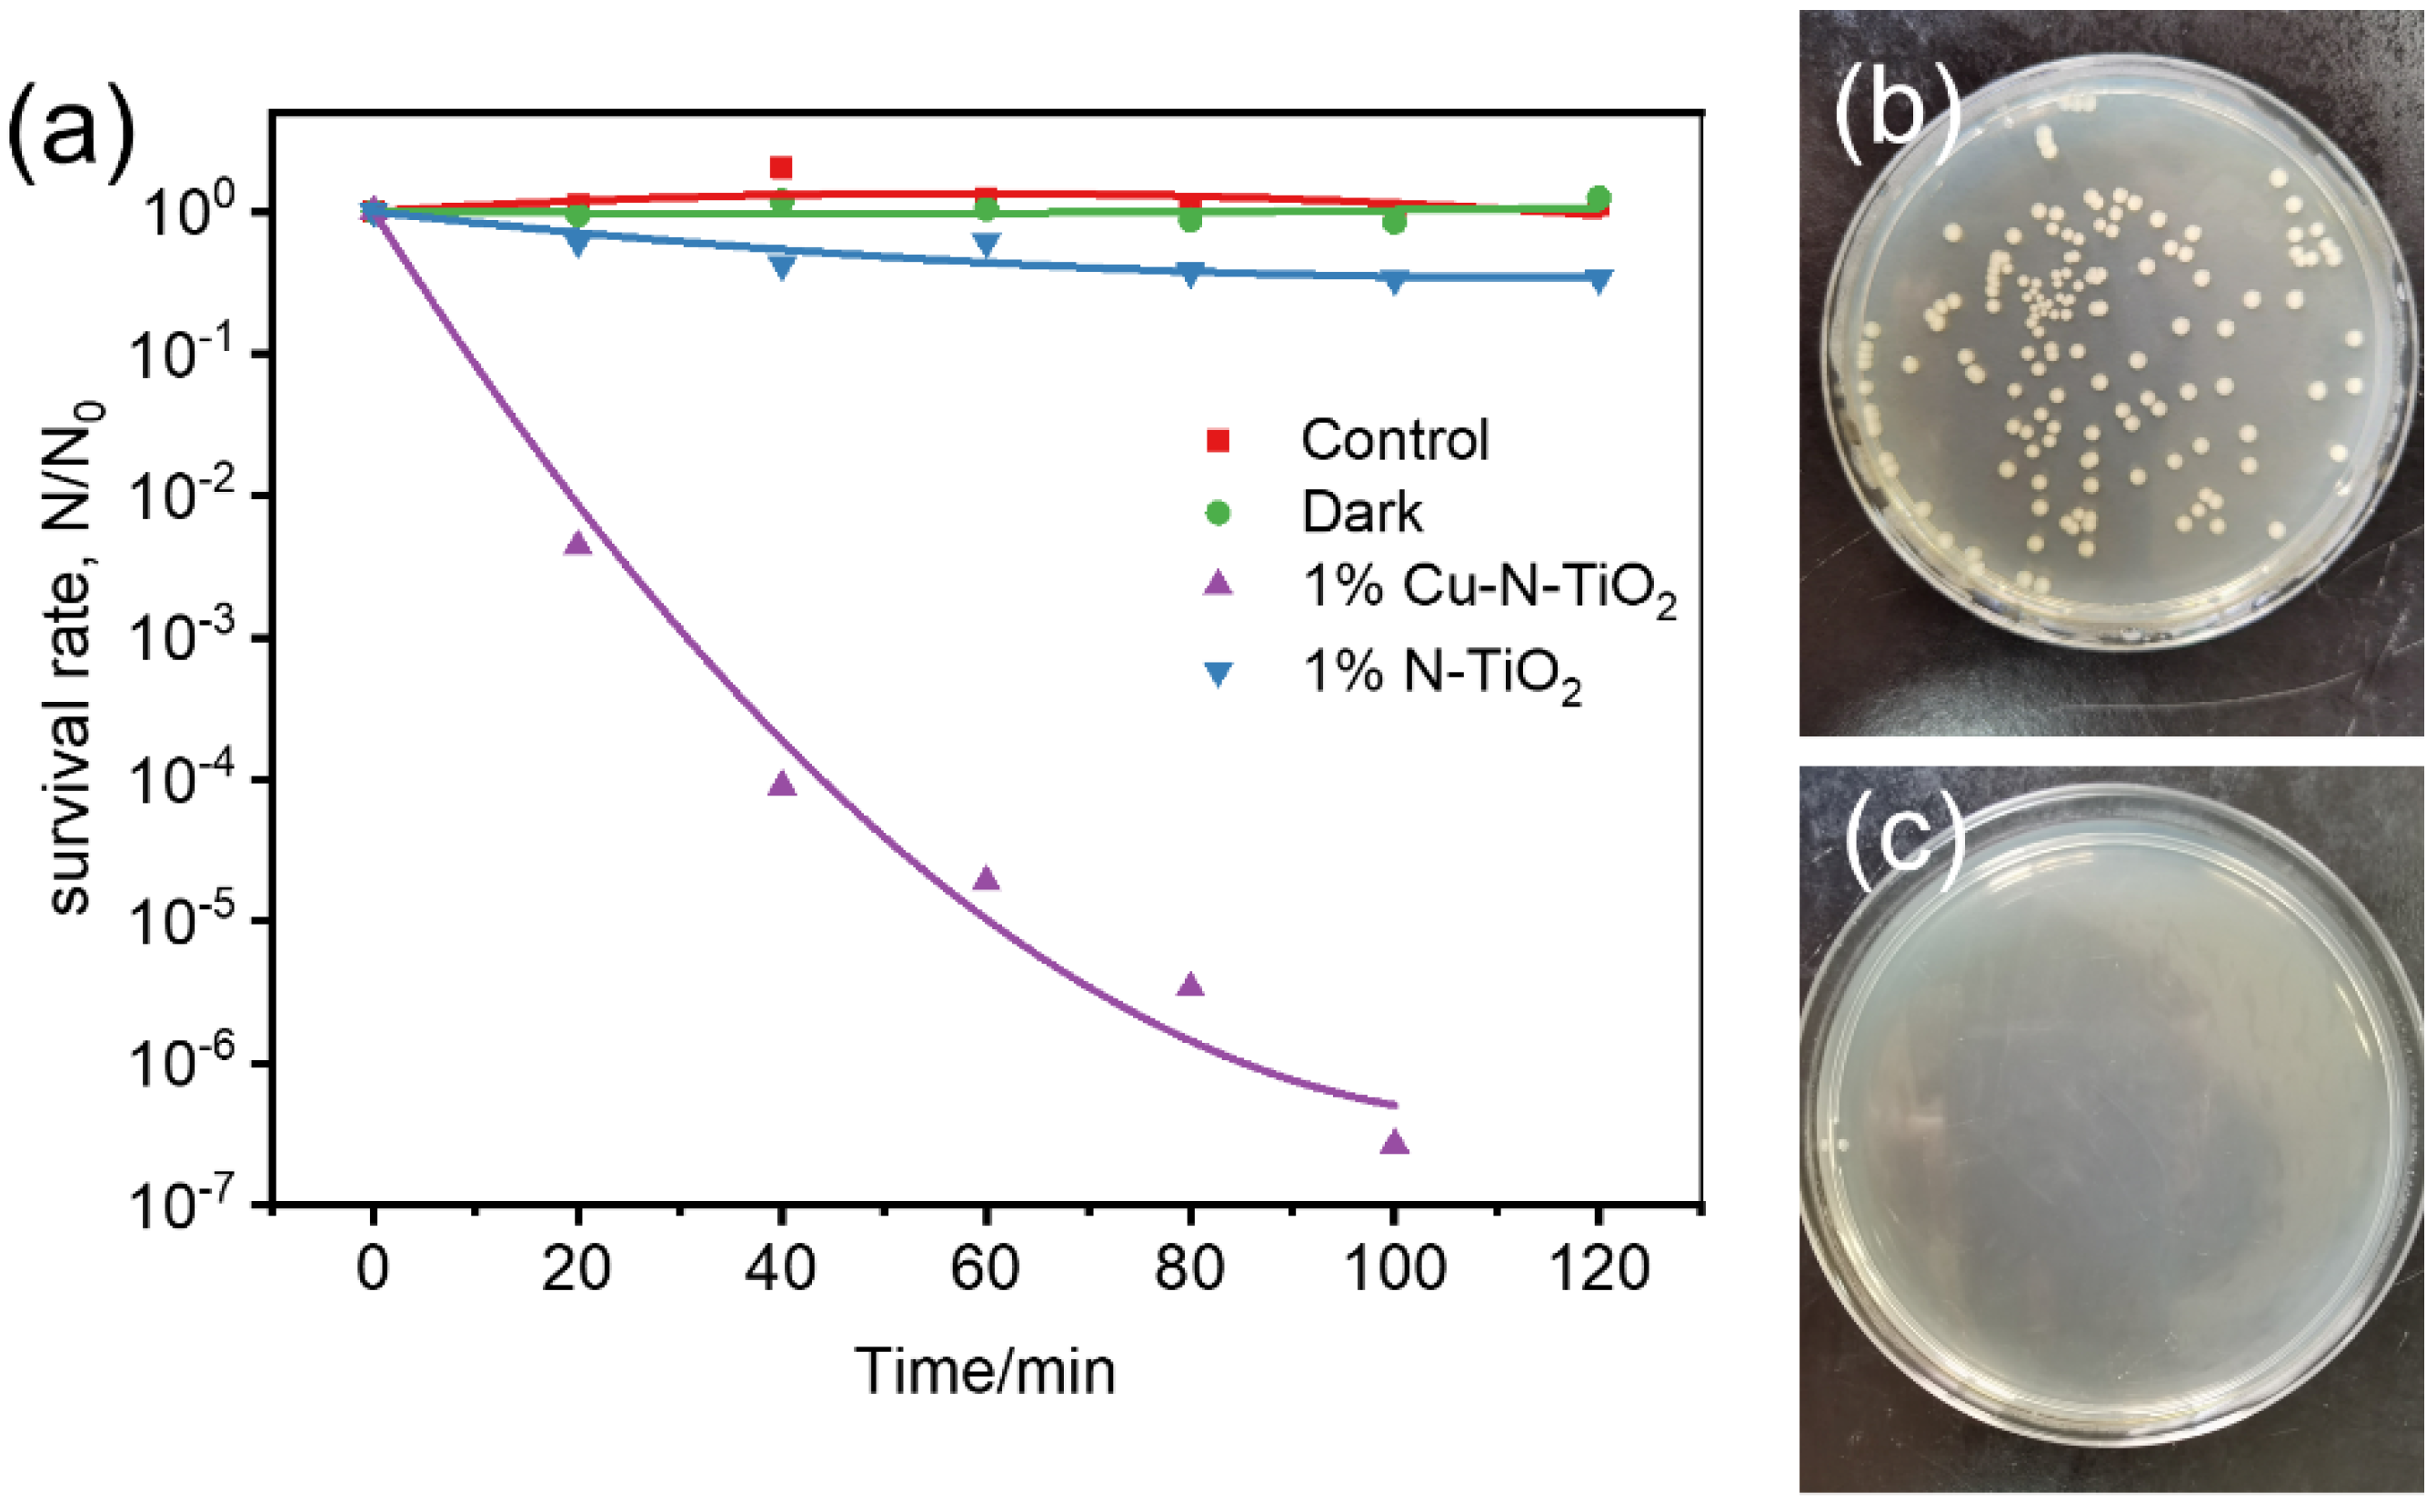
Molecules 26 06221 g007

Abstract
Developing efficient and cheap photocatalysts that are sensitive to indoor light is promising for the practical application of photocatalysis technology. Here, N-doped TiO2 photocatalyst with loaded Cu crystalline cocatalyst is synthesized by a simple one-pot method. The structure is confirmed by transmission electron microscopy and X-ray photoelectron spectroscopy analysis, which exhibit that Cu metal nanocrystalline is uniformly deposited on the surface of N-doped TiO2 material. UV-Vis absorption spectra illustrate that the modified samples possess favorable visible light absorption properties and suppressed-electron hole separation. The as-fabricated Cu-loaded N-TiO2 materials show high activity in photocatalytic decomposing isopropanol and inactivating E. coli under the irradiation of a household white LED lamp. The developed synthetic strategy and photocatalytic materials reported here are promising for indoor environment purification.
1. Introduction
Photocatalysis is regarded as a promising approach for removing pollutants and harmful microbes [1,2,3,4]. To achieve the widespread practical application of photocatalytic environment remediation, efficient photocatalysts that are sensitive to weak visible light, especially indoor light, are required [5,6]. Among the various semiconductor photocatalysts, titanium dioxide (TiO2) is one of the most promising materials for air purification and antibacterial functions due to its unique electronic band structures, prominent chemical stability, nontoxicity, and low cost [7,8]. However, TiO2 is a typical wide bandgap semiconductor (~3.2 eV), and it is only activated by ultraviolet (UV) irradiation [9,10]. Doping TiO2 with other elements is realized as an effective method to change the electronic band structure and, subsequently, the light absorption properties [11,12]. Over the past decades, the N-doped TiO2, which possesses hybridization of N 2p and O 2p orbits with re-constructed valence band, shows decreased bandgap and visible light sensitivity [13,14]. Up to now, the N-doped TiO2 is extensively studied as promising catalysts to decompose pollutants and microbes [15,16,17]; however, the activity is still unfavorable due to the easy recombination between photogenerated electrons and holes in bare materials [18,19]. To solve such a problem, loading cocatalysts such as Pt, Au, Ag, and other metals are effective in relieving the recombination of electron–hole pairs [20]. Especially, some non-noble metals such as Cu are more concerned as high activity and inexpensive cocatalyst materials to enhance the photocatalytic activity [21,22].
Up to now, the use of Cu metal cocatalysts to improve the photocatalytic activities over TiO2 materials has been widely reported. For example, Wu et al. prepared Cu particles deposited TiO2 by 400 °C calcination/reduction under H2 (3 mol% in N2) atmosphere after incipient-wetness impregnation, and the photocatalytic activity for hydrogen evolution was significantly enhanced [23]. Chiang et al. synthesized Cu nanoparticles deposited TiO2 nanorod composites by microwave-assisted sol–gel method and chemically reduced them with sodium borohydride as the reducing agent. The modified TiO2 enhanced the photocatalytic degradation of bisphenol A [24]; however, previous fabrication of cocatalyst of Cu metal on TiO2 is fabricated by mixture TiO2 and Cu2+ based salt at high temperature in the presence of H2. The TiO2 can also be reduced into TiO2−x and thus possibly decrease the intrinsic photocatalytic activity. The solvent reduction in the presence of sodium borohydride to reduce Cu2+ into Cu at mild conditions also seems effective; however, the process is sophisticated, and the reduced Cu metals usually have weak interaction with TiO2, which is not beneficial to the photocatalytic process. Developing a facile method to fabricate Cu catalysts on TiO2 with favorable photocatalytic activity is still limited.
In this study, the Cu-loaded on N-doped TiO2 were synthesized by the one-pot reaction method. In such a fabrication process, the TiO2 and Cu2+ salt simply mixed and then be nitridized in the presence of NH3 at 775 K. The NH3 at a high temperature can not only nitridize the TiO2 into N-doped TiO2, but also reduce the Cu2+ salt into Cu metal. The Cu metal loaded on N-TiO2 could thus be achieved by the one-pot procedure. The interaction between catalyst and cocatalyst was difficult using such a synthetic process, which benefits the photocatalytic reactions. The UV-Vis absorption spectrum shows that fabricated materials exhibit favorable visible light absorption. The modified samples have a remarkable enhancement in remediating gaseous pollutants and microbes under indoor commercial LED irradiation. The developed one-pot synthetic strategy and Cu-loaded N-TiO2 materials reported here are promising for the development of efficient photocatalysts for indoor environment purification.
2. Results and Discussion
The one-pot synthetic process is illustrated in Figure 1. Firstly, the Cu(NO3)2 and TiO2 were mixed and ground; the Cu(NO3)2 thus adsorbed on the surface of TiO2 nanoparticles. After that, the mixture was calcined under an ammonia atmosphere. The Cu(NO3)2 was reduced to Cu metal particles on the surface of TiO2 in such a process: NH3 → H2 + N2 and H2 + Cu2+ → Cu + 2H+. Meanwhile, a slight amount of N was doped into TiO2 to generate N-doped TiO2 (N-TiO2). Finally, the Cu metal-supported N-doped TiO2 was produced by the designed one-pot synthetic method. The products were expressed as xCu-N-TiO2 (the x represented the weight ratio of loaded Cu to N-TiO2).
Figure 1.
Scheme of synthesis of Cu metal loaded N-TiO2 by one-pot process.
The X-ray diffraction (XRD) patterns of the pristine TiO2, N-TiO2, and xCu-N-TiO2 samples are shown in Figure 2. All peaks of the as-prepared samples consist of anatase phases TiO2 (JCPDS card. 21-1272) without other impurity peaks observed [25]. The half-peak width of all products is not changed significantly, indicating that the crystallinity and grain size are almost kept. The copper and copper oxide are not observed, which is probably due to the fact that the amount of loaded Cu-based materials is too low to be detected by the XRD technical.
Figure 2.
XRD pattern of TiO2, N-TiO2, and xCu-N-TiO2 (x = 0.5%, 1%, and 2%).
Scanning electron microscopy (SEM) and transmission electron microscopy (TEM) were employed to characterize the morphologies and compositions of the as-prepared samples. Figure 3a and Figure S1 show the typical SEM images, which demonstrate that 1%Cu-N-TiO2, N-TiO2, and pristine TiO2 photocatalysts have nanoparticle-like morphology where the size of these particles is about 20–50 nm. After nitridation and Cu loading, the size and morphology of the TiO2 are not changed obviously. The TEM image in Figure 3b exhibits that materials of 1%Cu-N-TiO2 are uniformly dispersed nanoparticles, which is identical to the SEM results. The selected area electronic diffraction (SAED) pattern displays well resolved (101), (004), and (205) diffraction rings (inset of Figure 3b), which corresponds to the structural characteristic of anatase TiO2 [26]. The enlarged TEM image in Figure 3c further shows that the shape of each particle is an irregular shape with a narrow-distributed size from 20–50 nm. The high-resolution TEM (HRTEM) image of the product (Figure 3d) shows that the lattice fringe distance of the nanoparticles was measured as 0.35 and 0.36 nm, which corresponds to the (101) and (10) face of anatase TiO2, respectively. In addition, some nanoparticles with a size of about 4 nm are loaded on the surface of TiO2. As the HRTEM image illustrated, the lattice fringe is measured as 0.20 nm, which is consistent with the copper phase of Cu metal (111). Such a result indicates that the Cu metal nanoparticles are loaded on TiO2 nanocrystals. To further confirm that the Cu(NO3)2·3H2O can be converted into Cu metal under the designed synthetic condition, proper Cu(NO3)2·3H2O powder was calcined in ammonia atmosphere under 500 °C without the addition of TiO2. The XRD pattern in Figure S2 shows that all peaks were assigned to Cu metal. So, the Cu nanocrystalline loaded on N-doped TiO2 nanoparticles is reasonable in our materials synthesis route.
Figure 3.
(a) SEM, (b–d) TEM, and SAED (inset) images of 1%Cu-N-TiO2.
In the following study, the Cu states in 1%Cu-N-TiO2 were determined through the Cu 2p XPS spectra. As shown in Figure 4a, the product of 1%Cu-N-TiO2 displays one main peak located at 932.47 eV, which could be assigned to Cu0 state [21]. Such a result suggests that the synthesized product is loaded with Cu metal. XPS element content analysis (Table S1) exhibits that the amount of loaded Cu is about 2 wt%, which is higher than the designed amount in our synthetic experiment. The variety in the amount of loaded may be because the XPS is a surface analysis technology, which detects the atoms on and near surface, which leads to the higher value of loaded Cu. The formed Cu metal nanoparticle on TiO2 may partly be oxidized into the oxidation state of Cu2O or CuO once it is exposed to air conditions; however, these characterizations show that the oxidation states of Cu, such as the CuO and Cu2O, are not obvious. Figure 4b presents the XPS spectra of N1s state in N-TiO2 and 1%Cu-N-TiO2 samples. The binding energy range of N1s peaks is 396–404 eV, which is a typical N 1s XPS spectra for N-doped TiO2 [27]. The binding energies of both samples are at 399.6 eV, which is considered as the form of Ti–N–O bonds [27,28]. So, the N element has been successfully doped into the TiO2. Figure 4c and d present the XPS spectra of Ti 2p and O1s state in N-TiO2 and 1%Cu-N-TiO2 samples. The peak strength and peak position of the Ti 2p and O1s XPS spectra of the two samples were almost unchanged, indicating that Cu nanoparticles were only deposited on the surface of N-TiO2 photocatalyst, which did not influence the chemical states of Ti and O.
Figure 4.
XPS spectra of: (a) Cu2p for 1%Cu-N-TiO2 (b) N1s; (c) Ti2p; (d) O1s for N-TiO2 and 1%Cu-N-TiO2.
The UV-Vis absorption spectra of as-prepared materials were studied. Figure 5a shows that pristine TiO2 have an absorption edge at about 380 nm. The N-doped TiO2 products have much wider absorption edges. Figure 5b shows the enlarged areas from Figure 5a. It is observed that the N-TiO2 and the Cu loaded can N-TiO2 reach the absorption edge at about 540–560 nm. So, the light absorption ability is significantly enhanced. This can be attributed to the formation of a local intermediate band (N 2p) energy level at the top of the O 2p valence band in TiO2 by the N introduction. The band gap of the semiconductor is narrowed so that longer wavelengths of light can be absorbed to form photogenerated electrons and holes [29,30]. It is worth noting that the loaded Cu metal particles have no obvious enhancement on the UV–Vis absorption spectra, which is attributed to the fact that the Cu element was only loaded on the surface of TiO2, which did not change the electronic energy band structure of TiO2.
Figure 5.
(a) UV-visible absorption spectrum and (b) the enlarged spectrum at 350–450 nm of pristine TiO2, N- TiO2, and xCu-N-TiO2 nanocomposites (x = 0.5%, 1%, 2%).
The degradation of gaseous isopropanol (IPA) under white LED light irradiation is evaluated to reflect the photocatalytic performance of the prepared materials. IPA was chosen as the target molecule because it is a representative volatile organic compound for gaseous pollutants [31]. The wavelength of the indoor commercial white LED light used as a light source with a wavelength of 400–700 nm and light intensity of approximately 8 mW/cm2 (Figure S3). Figure 6a shows a comparative study of the photocatalytic activity of acetone increases at full speed in the first 80 min over N-TiO2 and different Cu loaded N-TiO2 products. It could be found that the evolution rates of acetone over 2%Cu-N-TiO2, 1%Cu-N-TiO2, 0.5%Cu-N-TiO2, and N-TiO2 reach about 420.0, 662.3, 364.5, and 70.0 ppm h−1, respectively. The 1%Cu-N-TiO2 shows the best activity in the decomposing IPA, which is about 9.5 folds as N-TiO2. Obviously, Cu nanoparticles on the surface of N-TiO2 can act as cocatalysts and suppresses the recombination of the photogenerated hole–electron pairs, which improve the photocatalytic activity [32]. Figure 6b shows a complete process of IPA degradation under an LED light. Firstly, the concentration of IPA decrease fast with and the concentration of acetone increase rapidly (CH3CHOHCH3 + e− + O2 + H+ → CH3COCH3 + HO· + H2O or CH3CHOHCH3 + h+ → CH3COCH3+ 2H+ + e−) [33]. When the concentration of acetone reaches a maximum level, the concentration of acetone starts to be decomposed into CO2, and the evolved CO2 increases rapidly. Finally, the evolved concentration of CO2 reaches about three times as initial concentration of IPA, indicating that 1%Cu-N-TiO2 photocatalyst can mineralize IPA to CO2 completely (CH3CHOHCH3 + 5H2O + 18h+ → 3CO2 + 18H+) [33,34].
Figure 6.
(a) Comparative studies of full speed acetone production over bare N-TiO2, and xCu-N-TiO2 (x = 0.5%, 1%, and 2%) samples under the same conditions; (b) representative time-dependent gas concentrations during IPA decomposition over 1%Cu-N-TiO2 sample under LED light irradiation.
The Brunner−Emmet−Teller (BET) specific surface areas of the 1%Cu-N-TiO2 and N-TiO2 were determined using N2 adsorption and desorption isotherms (Figure S4). The BET surface area of N-doped TiO2 and 1%Cu-N-TiO2 are approximate 29.7 and 31.9 m2g−1, which are quite closed. So, the degradation of activity is thus mainly influenced by the loading of Cu rather than the surface areas.
In the following study, the sterilization performance of 1%Cu-N-TiO2 was evaluated under irradiation of indoor LED light. E. coli is one of the most common bacteria as a model microbe to evaluate the inactivation performance for many sterilization materials [35]. Figure 7a shows the corresponding activities of 1%Cu-N-TiO2 and N-TiO2. The survival rate of E. coli over 1%Cu-N-TiO2 reaches 10−7 after 100 min, shows that the E. coli is completely sterilized. For comparison, the survival rate of E. coli over N-TiO2 is only 0.33 in 100 min. So, the 1%Cu-N-TiO2 shows much enhanced activity compared to N-TiO2. In addition, the control experiments were carried out to prove that the sterilization effect is caused by the photocatalytic process over 1%Cu-N-TiO2. When the 1%Cu-N-TiO2 photocatalyst is placed in the bacterial culture medium under dark conditions, the bacteria surviving is closer to 100% after 120 min. So, there is no toxic effect of Cu-N-TiO2 on E. coli cells under dark conditions. When the bacterial medium is placed under LED light irradiation without catalyst, there is no obvious decrease in E. coli cells after 120 min. So, the activity is certain from the photocatalytic effects. Figure 7b,c show the images of E. coli colonies on agar plates before (diluted 105 times) and after (not diluted) LED light irradiation for 100 min in the presence of 1%Cu-N-TiO2. During the photocatalytic process, the photogenerated electrons and holes pairs react with water to produce reactive oxygen species. The reactive oxygen species include HO•, O2•−, HO2•, etc., and can destroy the E. coli cell and results in bacterial inactivation [3].
Figure 7.
(a) Photocatalytic inactivation efficiency against E. coli (1 × 107 cfu mL−1, 50 mL) in the presence of 1%Cu-N-TiO2 and N-TiO2 under LED light irradiation and control experiments; images of E. coli colonies on an agar plate (b) before (diluted 105 times) and (c) after (not diluted) LED light irradiation for 120 min in the presence of 1%Cu-N-TiO2.
Figure 8 shows a scheme of as-prepared 1% Cu-N-TiO2 for decomposition of IPA and inactivation of E. coli. Nitrogen doping forms an intermediate energy level on the top of the valence band in TiO2 semiconductors, which shifts the absorption of light to the visible light region and induces the semiconductor to generate photogenerated electrons and holes under LED irradiation. The Cu metal nanoparticles act as a cocatalyst material on the surface of N-doped TiO2 photocatalysts, which suppress the recombination of photogenerated electrons and holes. In addition, the metal state Cu can also act as electrons storage centers to promote multi-electron reactions. The photocatalytic decomposition of IPA and inactivation of E. coli efficiency is thus significantly improved under the irradiation of white LED light.
Figure 8.
Schematic illustration of electronic bands structure and redox reactions over Cu loaded N-TiO2 catalysts.
3. Materials and Methods
3.1. Preparation of Photocatalysts
In a typical process, 1.0 g TiO2 (anatase phase, 10–25 nm grain size, Sigma-Aldrich Co. St. Louis, MO, USA) and Cu(NO3)2·3H2O (AR, Sinopharm Chemical Reagent Co., Ltd., Shanghai, China) were well mixed with a certain ratio and ground. The mixture was calcined at 773 K for about 3 h under an ammonia atmosphere to obtain Cu metal-loaded N-doped TiO2 nanoparticles (xCu-N-TiO2). For comparison, pure TiO2 powder was also calcined at 773 K in an ammonia atmosphere for 3 h without Cu, which was expressed as N-TiO2.
3.2. Photocatalytic Degradation of Pollutants
The photocatalytic decomposition of gaseous isopropanol (IPA) was evaluated under white LED illumination. Figure S5 shows the reaction cell used in IPA degradation experiments. In a typical procedure, a 600 mL glass container was used as the photocatalytic vessel reactor. A commercial white LED (30 W, OPPLE, Shanghai, China) was located at 10 cm from the vessel reactor. About 100 mg photocatalysts were dispersed in a 9.5 cm2 circular glass dish, which was located in the center of the vessel reactor. The reactor was filled with fresh synthetic air (20% oxygen and 80% nitrogen) for 1 h. The pressure inside the reactor was kept at 1 Kpa (Atmospheric pressure). Then, about 1000 ppm of gaseous IPA was injected into the reactor. The reactor was placed in darkness for 3 h to reach adsorption equilibrium. When the concentration of IPA remained constant, the adsorption equilibrium of IPA was considered to have been reached. During the process of IPA adsorption equilibrium, no products such as acetone or CO2 were detected, indicating that the gaseous IPA could not be degraded by photocatalyst under dark conditions. The reactor was then irradiated with an LED lamp, and 0.5 mL products along the reactions were regularly extracted from the reactor. The concentrations of IPA, acetone, and CO2 were measured by a gas chromatograph (GC-2014, Shimadzu, Kyoto, Japan).
3.3. Evaluation of Anti-Bacteria
The anti-bacteria activities of photocatalysts were evaluated by killing E. coli cells. The E. coli was cultured in Luria Bertani (LB) nutrient medium at 37 °C and shocked for 24 h. Then, the cultured E. coli cells were washed by centrifugation at 5000 rpm and were resuspended and diluted to ~1 × 107 cfu (colony forming unit)/mL in sterilized 0.9% saline solution. All glass apparatuses and consumables used in the experiments were sterilized in an autoclave at 121 °C for 25 min. About 30 mg photocatalyst was added to a glass reactor containing 30 mL diluted E. coli suspension. The reaction mixture was covered with quartz glass and stirred during the experiment. The light source was also produced from a commercial white LED (30 W, OPPLE) which was located 15 cm from the E. coli solution. The experimental temperature of photocatalysis was kept at about 25 °C by circulating cooling water. At regular intervals, an aliquot of the reaction solution was collected and diluted with saline solution, and 0.1 mL of the diluted solution was spread on a nutrient agar plate. The diluted E. coli cells were incubated at 37 °C for 24 h and then the number of viable cells was determined by counting colonies.
4. Conclusions
In summary, the Cu metal nanocrystalline-loaded N-TiO2 photocatalysts were synthesized by a simple one-pot method. TEM, XPS, and UV-Vis absorption spectra confirm that Cu metal nanocrystalline is successfully deposited on N-doped TiO2 photocatalysts and exhibits favorable visible light absorption ability. Under the irradiation of indoor white LED light, the IPA photodegradation rate over optimal 1%Cu-N-TiO2 is about 662.3 ppm h−1, which is about 9.5 folds as N-doped TiO2 (70.0 ppm h−1). The E. coli could be completely killed by 1%Cu-N-TiO2 under LED light irradiation in 120 min, which is significantly improved in comparison with N-TiO2. The developed synthetic strategy and photocatalytic materials reported here are promising for the development of photocatalysts for indoor environment purification.
Supplementary Materials
Figure S1: SEM images of (a–c) pristine TiO2, (d–f) N-TiO2, and (g–h) 1%Cu-N-TiO2. Figure S2: XRD pattern of product by nitridizing Cu(NO3)2·3H2O powder under 773 K for about 3 h under NH3 gas atmosphere. Figure S3: The irradiation spectrum of used white LED lamp. Figure S4: Nitrogen adsorption-desorption isotherms and calculated BET specific surface areas of the 1%Cu-N-TiO2 and N-TiO2. Figure S5: The reaction cell used for isopropanol degradation experiments. Table S1: XPS element content analysis of 1%Cu-N-TiO2.
Author Contributions
Conceptualization, N.Z.; methodology, N.Z. and S.W.; software, Y.P.; validation, Y.P., Y.W. and Y.C.; formal analysis, Y.P.; investigation, Y.W.; resources, Y.P.; data curation, Y.P. and N.Z.; writing—original draft preparation, Y.P.; writing—review and editing, N.Z.; visualization, N.Z.; supervision, N.Z. and X.Z.; project administration, N.Z.; funding acquisition, N.Z. All authors have read and agreed to the published version of the manuscript.
Funding
This work received financial support from the Key Special Focus Project of China Hunan Provincial Science and Technology Department (Grant No. 2020SK3025), Changsha Municipal Natural Science Foundation (kq2014119), and Opening Project of Guangdong Provincial Key Laboratory of Technique and Equipment for Macromolecular Advanced Manufacturing, South China University of Technology, China (2020kfkt02).
Institutional Review Board Statement
Not applicable.
Informed Consent Statement
Not applicable.
Conflicts of Interest
The authors declare no conflict of interest.
Sample Availability
Samples of the compounds are available from the authors.
References
- Gaya, U.I.; Abdullah, A.H. Heterogeneous photocatalytic degradation of organic contaminants over titanium dioxide: A review of fundamentals, progress and problems. J. Photochem. Photobiol. C Photochem. Rev. 2008, 9, 1–12. [Google Scholar] [CrossRef]
- Vohra, A.; Goswami, D.Y.; Deshpande, D.A.; Block, S.S. Enhanced photocatalytic disinfection of indoor air. Appl. Catal. B Environ. 2006, 64, 57–65. [Google Scholar] [CrossRef]
- Laxma Reddy, P.V.; Kavitha, B.; Kumar Reddy, P.A.; Kim, K.H. TiO2-based photocatalytic disinfection of microbes in aqueous media: A review. Environ. Res. 2017, 154, 296–303. [Google Scholar] [CrossRef] [PubMed]
- Baruah, S.; Dutta, J. Nanotechnology applications in pollution sensing and degradation in agriculture. Environ. Chem. Lett. 2009, 7, 191–204. [Google Scholar] [CrossRef]
- Qiu, X.; Miyauchi, M.; Sunada, K.; Minoshima, M.; Liu, M.; Lu, Y.; Li, D.; Shimodaira, Y.; Hosogi, Y.; Kuroda, Y.; et al. Hybrid CuxO/TiO2 Nanocomposites As Risk-Reduction Materials in Indoor. ACS Nano 2012, 6, 1609–1618. [Google Scholar] [CrossRef]
- Pelaez, M.; Nolan, N.T.; Pillai, S.C.; Seery, M.K.; Falaras, P.; Kontos, A.G.; Dunlop, P.S.M.; Hamilton, J.W.J.; Byrne, J.A.; O’Shea, K.; et al. A review on the visible light active titanium dioxide photocatalysts for environmental applications. Appl. Catal. B Environ. 2012, 125, 331–349. [Google Scholar] [CrossRef] [Green Version]
- Fujishima, A.; Zhang, X.; Tryk, D.A. TiO2 photocatalysis and related surface phenomena. Surf. Sci. Rep. 2008, 63, 515–582. [Google Scholar] [CrossRef]
- Hashimoto, K.; Irie, H.; Fujishima, A. TiO2 photocatalysis: A historical overview and future prospects. Jpn. J. Appl. Phys. 2005, 44, 8269–8285. [Google Scholar] [CrossRef]
- Ni, M.; Leung, M.K.H.; Leung, D.Y.C.; Sumathy, K. A review and recent developments in photocatalytic water-splitting using TiO2 for hydrogen production. Renew. Sustain. Energy Rev. 2007, 11, 401–425. [Google Scholar] [CrossRef]
- Ohno, T.; Akiyoshi, M.; Umebayashi, T.; Asai, K.; Mitsui, T.; Matsumura, M. Preparation of S-doped TiO2 photocatalysts and their photocatalytic activities under visible light. Appl. Catal. A Gen. 2004, 265, 115–121. [Google Scholar] [CrossRef]
- Ren, W.; Ai, Z.; Jia, F.; Zhang, L.; Fan, X.; Zou, Z. Low temperature preparation and visible light photocatalytic activity of mesoporous carbon-doped crystalline TiO2. Appl. Catal. B Environ. 2007, 69, 138–144. [Google Scholar] [CrossRef]
- Basavarajappa, P.S.; Patil, S.B.; Ganganagappa, N.; Reddy, K.R.; Raghu, A.V.; Reddy, C.V. Recent progress in metal-doped TiO2, non-metal doped/codoped TiO2 and TiO2 nanostructured hybrids for enhanced photocatalysis. Int. J. Hydrogen Energy 2020, 45, 7764–7778. [Google Scholar] [CrossRef]
- Asahi, R.; Morikawa, T.; Ohwaki, T.; Aoki, K.; Taga, Y. Visible-light photocatalysis in nitrogen-doped titanium oxides. Science 2001, 293, 269–271. [Google Scholar] [CrossRef]
- Rengifo-Herrera, J.A.; Mielczarski, E.; Mielczarski, J.; Castillo, N.C.; Kiwi, J.; Pulgarin, C. Escherichia coli inactivation by N, S co-doped commercial TiO2 powders under UV and visible light. Appl. Catal. B Environ. 2008, 84, 448–456. [Google Scholar] [CrossRef]
- Chen, X.; Xie, Z.; Liang, Y.; Wei, J.; Zhu, Y.; Huo, Y.; Zhang, X.; Wang, H. Hybridizing TiO2 with Nitrogen-Doped Carbon: A New Route to A Highly Visible Light-Active Photocatalyst. ChemistrySelect 2017, 2, 1565–1572. [Google Scholar] [CrossRef]
- Li, G.; Zou, B.; Feng, S.; Shi, H.; Liao, K.; Wang, Y.; Wang, W.; Zhang, G. Synthesis of N-Doped TiO2 with good photocatalytic property. Phys. B Condens. Matter 2020, 588, 412184. [Google Scholar] [CrossRef]
- Dunnill, C.W.; Parkin, I.P. Nitrogen-doped TiO2 thin films: Photocatalytic applications for healthcare environments. Dalton Trans. 2011, 40, 1635–1640. [Google Scholar] [CrossRef] [PubMed]
- Kumar, S.G.; Devi, L.G. Review on modified TiO2 photocatalysis under UV/visible light: Selected results and related mechanisms on interfacial charge carrier transfer dynamics. J. Phys. Chem. A 2011, 115, 13211–13241. [Google Scholar] [CrossRef]
- Low, J.; Yu, J.; Jaroniec, M.; Wageh, S.; Al-Ghamdi, A.A. Heterojunction Photocatalysts. Adv. Mater. 2017, 29. [Google Scholar] [CrossRef] [PubMed]
- Tada, H.; Kiyonaga, T.; Naya, S.I. Rational design and applications of highly efficient reaction systems photocatalyzed by noble metal nanoparticle-loaded titanium(IV) dioxide. Chem. Soc. Rev. 2009, 38, 1849–1858. [Google Scholar] [CrossRef]
- Zhai, S.; Yang, X.; Tang, M.; Gu, W.; Teng, F. Facile Synthesis of Cu Quantum Dots-TiO2 Nanosheets Schottky Junction and Improved Photocatalytic Degradation Activity. ChemistrySelect 2020, 5, 5693–5700. [Google Scholar] [CrossRef]
- Hao, W.; Zhao, L.; Li, X.; Qin, L.; Han, S.; Kang, S.Z. Cu nanoclusters incorporated mesoporous TiO2 nanoparticles: An efficient and stable noble metal-free photocatalyst for light driven H2 generation. Int. J. Hydrogen Energy 2021, 46, 6461–6473. [Google Scholar] [CrossRef]
- Wu, N.L.; Lee, M.S. Enhanced TiO2 photocatalysis by Cu in hydrogen production from aqueous methanol solution. Int. J. Hydrogen Energy 2004, 29, 1601–1605. [Google Scholar] [CrossRef]
- Chiang, L.F.; Doong, R. An Cu-TiO2 nanorods with enhanced ultraviolet- and visible-light photoactivity for bisphenol A degradation. J. Hazard. Mater. 2014, 277, 84–92. [Google Scholar] [CrossRef] [PubMed]
- Gu, L.; Wang, J.; Cheng, H.; Du, Y.; Han, X. Synthesis of nano-sized anatase TiO2 with reactive (001) facets using lamellar protonated titanate as precursor. Chem. Commun. 2012, 48, 6978–6980. [Google Scholar] [CrossRef] [PubMed]
- Miao, L.; Tanemura, S.; Toh, S.; Kaneko, K.; Tanemura, M. Heating-sol-gel template process for the growth of TiO2 nanorods with rutile and anatase structure. Appl. Surf. Sci. 2004, 238, 175–179. [Google Scholar] [CrossRef]
- Xu, T.; Wang, M.; Wang, T. Effects of N Doping on the Microstructures and Optical Properties of TiO2. J. Wuhan Univ. Technol.-Mater. Sci. Ed. 2019, 34, 55–63. [Google Scholar] [CrossRef]
- Yang, G.; Jiang, Z.; Shi, H.; Xiao, T.; Yan, Z. Preparation of highly visible-light active N-doped TiO2 photocatalyst. J. Mater. Chem. 2010, 20, 5301–5309. [Google Scholar] [CrossRef]
- Di Valentin, C.; Pacchioni, G.; Selloni, A.; Livraghi, S.; Giamello, E. Characterization of paramagnetic species in N-doped TiO2 powders by EPR spectroscopy and DFT calculations. J. Phys. Chem. B 2005, 109, 11414–11419. [Google Scholar] [CrossRef]
- Di Valentin, C.; Pacchioni, G.; Selloni, A. Origin of the different photoactivity of N-doped anatase and rutile TiO2. Phys. Rev. B-Condens. Matter Mater. Phys. 2004, 70, 1–4. [Google Scholar] [CrossRef]
- Wolkoff, P.; Nielsen, G.D. Organic compounds in indoor air-their relevance for perceived indoor air quality? Atmos. Environ. 2001, 35, 4407–4417. [Google Scholar] [CrossRef]
- Ombaka, L.M.; Curti, M.; McGettrick, J.D.; Davies, M.L.; Bahnemann, D.W. Nitrogen/Carbon-Coated Zero-Valent Copper as Highly Efficient Co-catalysts for TiO2Applied in Photocatalytic and Photoelectrocatalytic Hydrogen Production. ACS Appl. Mater. Interfaces 2020, 12, 30365–30380. [Google Scholar] [CrossRef] [PubMed]
- Ouyang, S.; Ye, J. β-AgAl1-xGaxO2 solid-solution photocatalysts: Continuous modulation of electronic structure toward high-performance visible-light photoactivity. J. Am. Chem. Soc. 2011, 133, 7757–7763. [Google Scholar] [CrossRef] [PubMed]
- Arsac, F.; Bianchi, D.; Chovelon, J.M.; Ferronato, C.; Herrmann, J.M. Experimental microkinetic approach of the photocatalytic oxidation of isopropyl alcohol on TiO2. Part 1. Surface elementary steps involving gaseous and adsorbed C3HxO species. J. Phys. Chem. A 2006, 110, 4202–4212. [Google Scholar] [CrossRef] [PubMed]
- Venieri, D.; Fraggedaki, A.; Kostadima, M.; Chatzisymeon, E.; Binas, V.; Zachopoulos, A.; Kiriakidis, G.; Mantzavinos, D. Solar light and metal-doped TiO2 to eliminate water-transmitted bacterial pathogens: Photocatalyst characterization and disinfection performance. Appl. Catal. B Environ. 2014, 154–155, 93–101. [Google Scholar] [CrossRef] [Green Version]
Publisher’s Note: MDPI stays neutral with regard to jurisdictional claims in published maps and institutional affiliations. |
© 2021 by the authors. Licensee MDPI, Basel, Switzerland. This article is an open access article distributed under the terms and conditions of the Creative Commons Attribution (CC BY) license (https://creativecommons.org/licenses/by/4.0/).